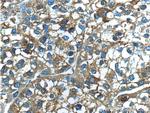
Ferritin light chain Antibody in Immunohistochemistry (Paraffin) (IHC (P))
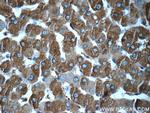
Ferritin light chain Antibody in Immunohistochemistry (Paraffin) (IHC (P))

Search
Proteintech
Ferritin light chain Polyclonal Antibody
{{$productOrderCtrl.translations['antibody.pdp.commerceCard.promotion.promotions']}}
{{$productOrderCtrl.translations['antibody.pdp.commerceCard.promotion.viewpromo']}}
{{$productOrderCtrl.translations['antibody.pdp.commerceCard.promotion.promocode']}}: {{promo.promoCode}} {{promo.promoTitle}} {{promo.promoDescription}}. {{$productOrderCtrl.translations['antibody.pdp.commerceCard.promotion.learnmore']}}
产品信息
10727-1-AP
种属反应
已发表种属
宿主/亚型
分类
类型
抗原
偶联物
形式
浓度
规格
纯化类型
保存液
内含物
保存条件
运输条件
产品详细信息
Immunogen sequence: MSSQIRQNY STDVEAAVNS LVNLYLQASY TYLSLGFYFD RDDVALEGVS HFFRELAEEK REGYERLLKM QNQRGGRALF QDIKKPAEDE WGKTPDAMKA AMALEKKLNQ ALLDLHALGS ARTDPHLCDF LETHFLDEEV KLIKKMGDHL TNLHRLGGPE AGLGEYLFER LTLKHD (1-175 aa encoded by B C008439)
靶标信息
This gene encodes the light subunit of the ferritin protein. Ferritin is the major intracellular iron storage protein in prokaryotes and eukaryotes. It is composed of 24 subunits of the heavy and light ferritin chains. Variation in ferritin subunit composition may affect the rates of iron uptake and release in different tissues. A major function of ferritin is the storage of iron in a soluble and nontoxic state. Defects in this light chain ferritin gene are associated with several neurodegenerative diseases and hyperferritinemia-cataract syndrome. This gene has multiple pseudogenes.
仅用于科研。不用于诊断过程。未经明确授权不得转售。
生物信息学
蛋白别名: epididymis secretory sperm binding protein; Ferritin L subunit; Ferritin L subunit 1; ferritin L-chain; Ferritin light chain; Ferritin light chain 1; ferritin light polypeptide-like 3; ferritin light subunit; ferritin, light polypeptide; fril; FTL; iron ion binding; unnamed protein product
基因别名: FTL; Ftl-1; FTL1; L-ferritin; LFTD; NBIA3
UniProt ID: (Human) P02792, (Rat) P02793
Entrez Gene ID: (Human) 2512, (Mouse) 14325, (Rat) 29292